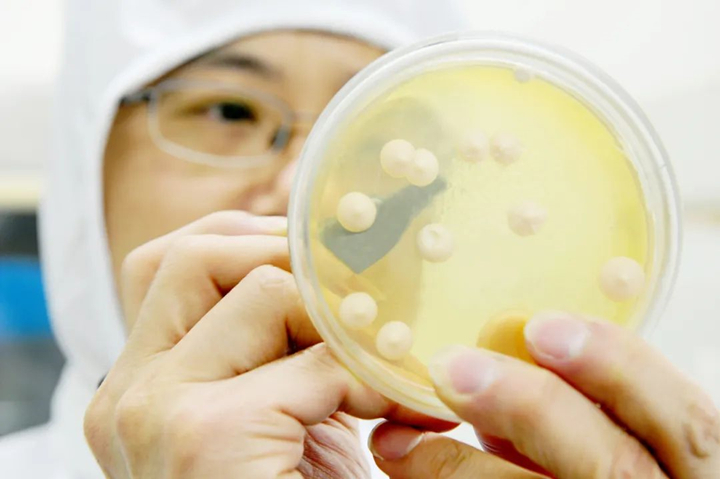
安琪公司以创新技术突围氮源困局

从隐患到高效:一场氮源替代之争
2025-02-13在奇妙的生物发酵世界里,数万亿微生物正日夜不息地工作着——它们将普通原料转化为抗生素,甚至你早餐的酸奶和面包,生物发酵的产物无处不在。而在这场无声的 “生产盛宴” 中,有机氮源扮演着举足轻重的角色。
氮源约占细菌干重的12%-15%,是构成蛋白质和核酸的主要原料。传统有机氮源虽能提供丰富营养,但其多为农副产品粗糙加工制得,原料来源把控和追溯缺失,生产工艺相对滞后,潜藏过敏源、转基因等诸多风险:
1.动物源产品存在动物疫病人际传播隐患;
2.黄豆饼粉利用率低,残留物处理成环保难题;
3.鱼粉易腐败残留组胺,威胁药品安全。
这些问题不仅推高生产成本,更制约着生物发酵产业的绿色转型。
一、破局者:安琪的氮源替代方案
面对行业痛点,安琪公司以创新技术突围氮源困局——通过精准替代与协同优化,开辟高效、安全、可持续的新路径。
(一)动物蛋白胨替代:安全与效价兼得

以庆大霉素项目为例,传统培养基依赖动物源蛋白胨,存在疫病传播风险。安琪与客户紧密合作,通过开展使用酵母粉替代的相关实验,不仅解决了产品的认证问题,还实现效价提升、成本下降以及安全环保的“三赢”局面。

(二)黄豆饼粉替代,综合提升原料利用效率

从绿色、高效制造的角度出发,使用酵母粉低比例替代部分黄豆饼粉,充分发挥酵母粉促生长及黄豆饼粉持续利用各自优势,协同作用,最终实现效价水平、原料成本双赢。以阿维菌素项目为例,使用酵母粉1:4替代30%黄豆饼粉后,保持效价情况下,原料成本降低超过10%。
(三)鱼粉革新:终结组胺残留难题
鱼粉,在饲料行业一直是优质蛋白质的重要来源。然而,其易腐败致组胺残留的问题曾让妥布霉素等药物生产如履薄冰。安琪研发的鱼粉替代方案,通过模拟鱼粉B族维生素与金属离子的组成特性,有效解决了组胺残留问题。该方案已通过多家客户小试、中试验证,即将投入量产。

二、未来:氮源的标准化与个性化并行
安琪公司的探索并未止步。未来,研发将聚焦两大方向:
标准化:建立氮源成分数据库,实现精准配比;
个性化:为不同菌种、产物定制专属氮源方案。
这场氮源革命,正推动生物发酵产业从“粗放加工”迈向“智能绿色”。作为微生物生长的理想营养库,有机氮源宛如一把“万能钥匙”,相信在众多科研人员和企业的共同努力下,有机氮源将不断创新升级,终将开启更高效、更可持续的绿色制造新时代。
从隐患到高效:一场氮源替代之争
2025-02-13在奇妙的生物发酵世界里,数万亿微生物正日夜不息地工作着——它们将普通原料转化为抗生素,甚至你早餐的酸奶和面包,生物发酵的产物无处不在。而在这场无声的 “生产盛宴” 中,有机氮源扮演着举足轻重的角色。
氮源约占细菌干重的12%-15%,是构成蛋白质和核酸的主要原料。传统有机氮源虽能提供丰富营养,但其多为农副产品粗糙加工制得,原料来源把控和追溯缺失,生产工艺相对滞后,潜藏过敏源、转基因等诸多风险:
1.动物源产品存在动物疫病人际传播隐患;
2.黄豆饼粉利用率低,残留物处理成环保难题;
3.鱼粉易腐败残留组胺,威胁药品安全。
这些问题不仅推高生产成本,更制约着生物发酵产业的绿色转型。
一、破局者:安琪的氮源替代方案
面对行业痛点,安琪公司以创新技术突围氮源困局——通过精准替代与协同优化,开辟高效、安全、可持续的新路径。
(一)动物蛋白胨替代:安全与效价兼得

以庆大霉素项目为例,传统培养基依赖动物源蛋白胨,存在疫病传播风险。安琪与客户紧密合作,通过开展使用酵母粉替代的相关实验,不仅解决了产品的认证问题,还实现效价提升、成本下降以及安全环保的“三赢”局面。
(二)黄豆饼粉替代,综合提升原料利用效率

从绿色、高效制造的角度出发,使用酵母粉低比例替代部分黄豆饼粉,充分发挥酵母粉促生长及黄豆饼粉持续利用各自优势,协同作用,最终实现效价水平、原料成本双赢。以阿维菌素项目为例,使用酵母粉1:4替代30%黄豆饼粉后,保持效价情况下,原料成本降低超过10%。
(三)鱼粉革新:终结组胺残留难题
鱼粉,在饲料行业一直是优质蛋白质的重要来源。然而,其易腐败致组胺残留的问题曾让妥布霉素等药物生产如履薄冰。安琪研发的鱼粉替代方案,通过模拟鱼粉B族维生素与金属离子的组成特性,有效解决了组胺残留问题。该方案已通过多家客户小试、中试验证,即将投入量产。

二、未来:氮源的标准化与个性化并行
安琪公司的探索并未止步。未来,研发将聚焦两大方向:
标准化:建立氮源成分数据库,实现精准配比;
个性化:为不同菌种、产物定制专属氮源方案。
这场氮源革命,正推动生物发酵产业从“粗放加工”迈向“智能绿色”。作为微生物生长的理想营养库,有机氮源宛如一把“万能钥匙”,相信在众多科研人员和企业的共同努力下,有机氮源将不断创新升级,终将开启更高效、更可持续的绿色制造新时代。